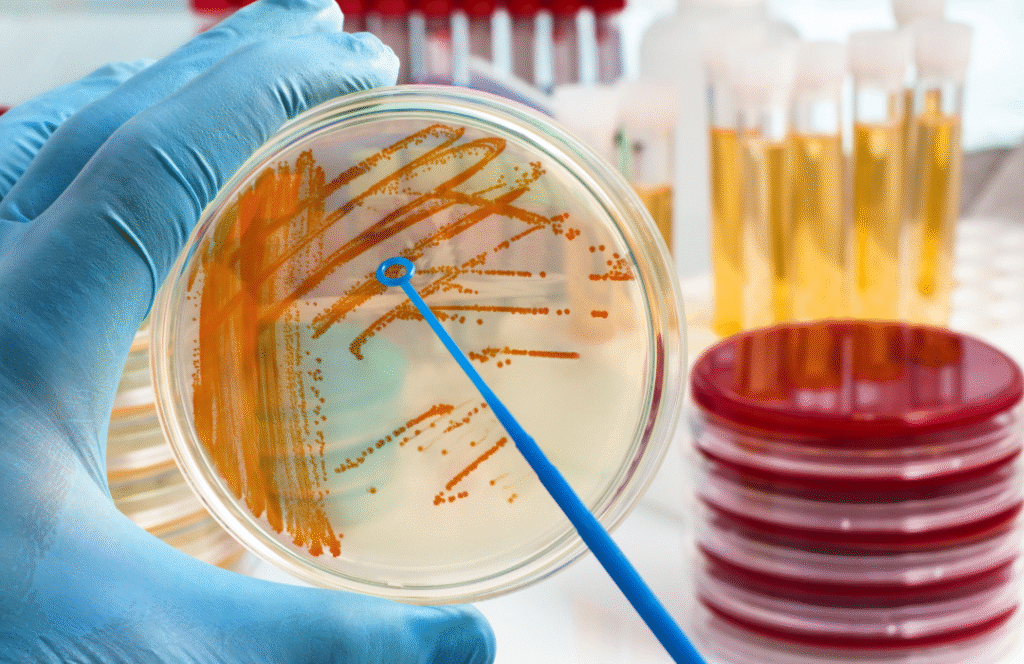

Your Trusted Partner in Food, Water, Microbiology Testing & Environmental Monitoring.
AZODI Labs, Accredited by NABL, offers reliable and high quality testing services across Food, Water, Microbiology, and Environmental industries. We are committed to delivering consistent, accurate results in line with global standards, without compromising on quality.
Our Services
We Transform Quality into
Business Growth
At AZODI Labs, we position products to stand stronger in the market with uncompromising quality. We deliver accurate and globally trusted results that boost ROI and customer confidence, empowering our clients to scale up, lead their industries, and set new benchmarks in quality.
Azodi Lab in Numbers
10
Years Of Experience
677
Parameters Tested
50
Clients
4900+
Total Samples Tested
Our Accreditation
Your Trusted Partner in Food, Water, Microbiology & Environmental Testing

Our Clients